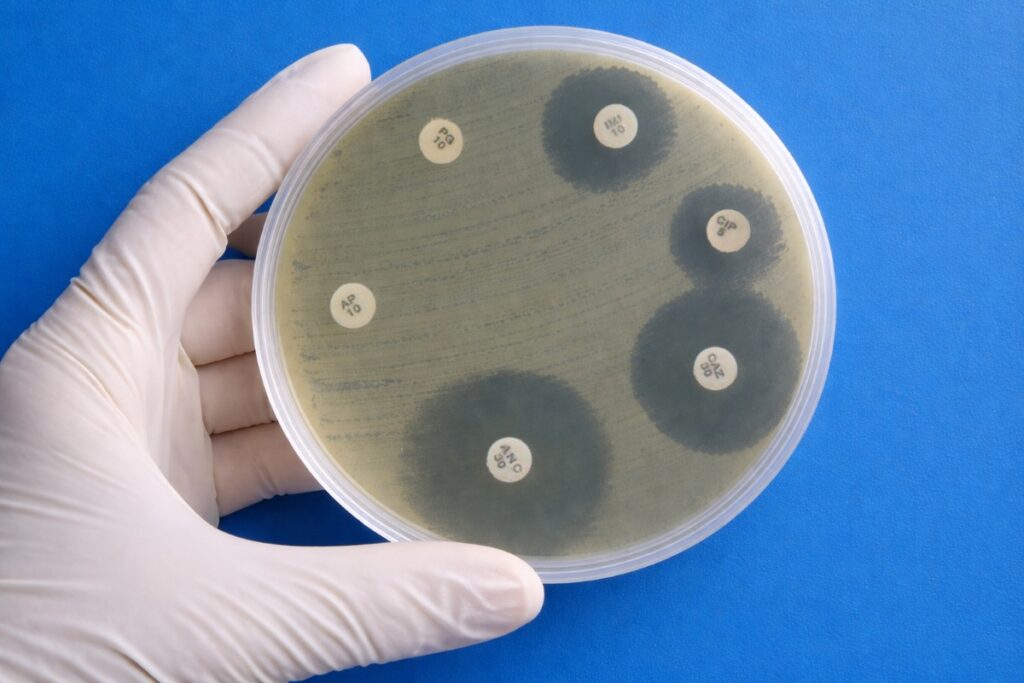
AMR susceptibility test: Bacteria showing resistance to Ceftazidime, Imipenem, and Ciprofloxacin in a lab culture.

Latest News
Cardiac Screening Saves Lives: A Decade of Data and the Case for Change
Dr Steven Cox, CEO of the research charity, Cardiac Risk in the Young (CRY) explains the key findings and importance of a seminal study (reviewing cardiac screening data collated over a 10 year period), published on 24 February 2026 in the Journal of the American...
Latest News
Pregnancy, the Brain, and the Nervous System
Pregnancy, the Brain, and the Nervous System: A Holistic Perspective on Perinatal Mental Health Pregnancy is often framed as a joyful milestone, yet from a clinical and neurobiological standpoint, it is one of the most significant periods of transformation a human...
Australian Healthcare Reviews Mean Nothing Without the Right Governance
Australians are making some of their most important healthcare decisions based on information that was never designed to carry that weight. For most Australians, searching for health information online and accessing test results digitally is already routine. Around 90...
GMCA: Why Unlocking Longevity Research Will Drive Innovation
The science of longevity has never been more active. With advances in preventive medicine and digital health, as well as new insights into lifestyle, environment, drug therapies and genetics, there is more research available than ever on how people age and live well....
Understanding GLP-1 Side Effects Through a Nutritional Lens
GLP-1 medications have changed the landscape of weight management. For many people, they have delivered clinically meaningful weight loss alongside improvements in glycaemic control, and their place in treatment pathways is now well established. What is becoming...
Join The Future Of Life Sciences Media
In a world overflowing with information, LifeScienceDaily.news stands apart as the dedicated space where life sciences professionals share what’s new, what’s next, and why it matters — all in real time.
Don’t wait for the media to pick up your story. Be the media.
Trending
More News
PICTURE: Democratising Clinical Intelligence from the Frontline
A New Era for EHR Data A new study published in the latest issue of the Royal College of Physicians’ Future Healthcare Journal introduces PICTURE, an innovative data platform designed to convert routine electronic health record (EHR) data into actionable clinical...
European Life Sciences: Rethinking the “Organic” US Expansion
Against a backdrop of rising development and launch costs, growing regulatory complexity, geopolitical uncertainty and intensifying competition for specialist talent, many European pharma and biotech companies are reassessing the long-held ambition of “cracking the...
Professor Chris Van Tulleken to Headline Smart Ageing Summit in May
After the success of previous summits, the revolutionary Smart Ageing Summit has announced a return to Oxford this May to host its fourth annual event. Rhodes House, University of Oxford is the perfect setting for non-profit organisation Oxford Health Project to host...
J&J to Invest Over $1B in Pennsylvania Cell Therapy Manufacturing Facility
Johnson & Johnson has announced plans to invest more than $1 billion in a new cell therapy manufacturing facility in Montgomery County, Pennsylvania. This project marks a significant expansion of its advanced therapies infrastructure and reinforces the company’s...
UK Expertise: Faster Cancer Diagnosis and Cleaner Energy
British research expertise to deliver faster cancer diagnosis and cleaner energy Major new backing for medical imaging centres across the UK alongside tidal energy testing expansion in Orkney and cutting-edge materials. From: Department for Science, Innovation and...
NIH Scientists Pioneer “Digital Twin” of Eye Cells
NIH Scientists Pioneer “Digital Twin” of Eye Cells: A New Frontier in Treating Age-Related Macular Degeneration In a landmark achievement for computational biology and ophthalmology, researchers at the National Institutes of Health (NIH) have announced the development...
The Evidence Behind Fertility Supplements: What the Research Actually Shows
Couples trying to conceive are bombarded with supplement recommendations. Scroll through any fertility forum and you'll find confident claims about CoQ10, vitamin D, and a dozen other compounds that supposedly hold the key to conception. Some of these recommendations...
Prices for GLP-1 Drugs Are Falling Fast and Forcing Companies to Adapt
The global market for GLP-1 receptor agonists, once defined by scarcity and premium pricing, is entering a new phase. Prices for these blockbuster medicines, used to treat obesity and type 2 diabetes, are beginning to fall rapidly, forcing pharmaceutical companies,...
AuDHD: Rethinking the Overlap Between Autism and ADHD
A Diagnostic Separation That Shaped a Generation For most of the modern history of psychiatry, autism and ADHD were treated as mutually exclusive conditions. Clinicians were trained to look for one or the other. Until the publication of DSM-5 in 2013, a dual diagnosis...
FDA Approves Commercial Manufacturing at Rezon Bio
Rezon Bio announces that its Warsaw-Duchnice facility has received approval from the U.S. Food and Drug Administration (FDA) for the commercial manufacturing of a biosimilar. This milestone represents an important step in the continued development of Rezon Bio's...
Doctors Warn AI Diet Advice Should Not Replace Medical Care
As more people turn to AI tools and online algorithms for diet and weight-loss advice, doctors are warning that this growing reliance may be overlooking critical health risks. Doctors stress that AI-generated information should never replace personalised medical...
Fertility Decisions and AI: Clarity Without False Certainty
As a researcher studying how people interact with large language models (LLMs), and as a clinician trained at the master’s level in clinical psychology, I keep seeing the same pattern in fertility and reproductive contexts. People rarely turn to AI only for...
PICTURE: Democratising Clinical Intelligence from the Frontline
A New Era for EHR Data A new study published in the latest issue of the Royal College of Physicians’ Future Healthcare Journal introduces PICTURE, an innovative data platform designed to convert routine electronic health record (EHR) data into actionable clinical...
European Life Sciences: Rethinking the “Organic” US Expansion
Against a backdrop of rising development and launch costs, growing regulatory complexity, geopolitical uncertainty and intensifying competition for specialist talent, many European pharma and biotech companies are reassessing the long-held ambition of “cracking the...
Professor Chris Van Tulleken to Headline Smart Ageing Summit in May
After the success of previous summits, the revolutionary Smart Ageing Summit has announced a return to Oxford this May to host its fourth annual event. Rhodes House, University of Oxford is the perfect setting for non-profit organisation Oxford Health Project to host...
J&J to Invest Over $1B in Pennsylvania Cell Therapy Manufacturing Facility
Johnson & Johnson has announced plans to invest more than $1 billion in a new cell therapy manufacturing facility in Montgomery County, Pennsylvania. This project marks a significant expansion of its advanced therapies infrastructure and reinforces the company’s...
UK Expertise: Faster Cancer Diagnosis and Cleaner Energy
British research expertise to deliver faster cancer diagnosis and cleaner energy Major new backing for medical imaging centres across the UK alongside tidal energy testing expansion in Orkney and cutting-edge materials. From: Department for Science, Innovation and...
NIH Scientists Pioneer “Digital Twin” of Eye Cells
NIH Scientists Pioneer “Digital Twin” of Eye Cells: A New Frontier in Treating Age-Related Macular Degeneration In a landmark achievement for computational biology and ophthalmology, researchers at the National Institutes of Health (NIH) have announced the development...
The Evidence Behind Fertility Supplements: What the Research Actually Shows
Couples trying to conceive are bombarded with supplement recommendations. Scroll through any fertility forum and you'll find confident claims about CoQ10, vitamin D, and a dozen other compounds that supposedly hold the key to conception. Some of these recommendations...
Prices for GLP-1 Drugs Are Falling Fast and Forcing Companies to Adapt
The global market for GLP-1 receptor agonists, once defined by scarcity and premium pricing, is entering a new phase. Prices for these blockbuster medicines, used to treat obesity and type 2 diabetes, are beginning to fall rapidly, forcing pharmaceutical companies,...
AuDHD: Rethinking the Overlap Between Autism and ADHD
A Diagnostic Separation That Shaped a Generation For most of the modern history of psychiatry, autism and ADHD were treated as mutually exclusive conditions. Clinicians were trained to look for one or the other. Until the publication of DSM-5 in 2013, a dual diagnosis...
FDA Approves Commercial Manufacturing at Rezon Bio
Rezon Bio announces that its Warsaw-Duchnice facility has received approval from the U.S. Food and Drug Administration (FDA) for the commercial manufacturing of a biosimilar. This milestone represents an important step in the continued development of Rezon Bio's...
Doctors Warn AI Diet Advice Should Not Replace Medical Care
As more people turn to AI tools and online algorithms for diet and weight-loss advice, doctors are warning that this growing reliance may be overlooking critical health risks. Doctors stress that AI-generated information should never replace personalised medical...
Fertility Decisions and AI: Clarity Without False Certainty
As a researcher studying how people interact with large language models (LLMs), and as a clinician trained at the master’s level in clinical psychology, I keep seeing the same pattern in fertility and reproductive contexts. People rarely turn to AI only for...
Featured Articles
Further News
Uniphar | Clinical merges with BMclinical
Leading global healthcare services provider Uniphar announces a strategic merger between Uniphar | Clinical and BMclinical, reinforcing Uniphar | Clinical’s integrated clinical supply offering and solidifying its position as a trusted partner to pharmaceutical and...
AI-Enabled Pathology: De-risking Oncology Drug Development
Today, oncology drug development continues to experience the highest attrition rates across therapeutic areas[1]. Despite major advances in molecular profiling and biomarker-driven strategies, a significant proportion of oncology clinical trials still fail, often due...
Why Sugar May Matter More Than We Thought
A New Energy-Centered Model of Metabolic Disease For decades, sugar has been framed as a problem of excess. Too many calories. Too many insulin spikes. Too much sweetness in the modern diet. That framing has shaped public health guidance, food reformulation, and...
Cera and Promptly Health Partner to Bridge the ‘Evidence Gap’
Cera, Europe’s largest digital-first home healthcare provider, has announced a global real-world evidence (RWE) partnership with Promptly Health, focused on the over-65s, to accelerate drug development and enable precision medicine. The partnership integrates Cera’s...
From Hype to Hard Science: Unlocking MSC Therapy’s Promise
After decades of promise and setbacks, advanced manufacturing platforms and robust Phase 2/3 trials are demonstrating whether MSCs can deliver transformative treatments for high-burden diseases Mesenchymal stromal cells (MSCs) have been called the most promising...
RCM Efficiency: Solving Insurance Denials & Margin Pressure
Insurance Denials and Revenue Cycle Inefficiencies Are Becoming a Primary Driver of Hospital Financial Strain U.S. hospitals are entering the next fiscal cycle under sustained financial pressure, and insurance denials have emerged as one of the most consequential, yet...
Thousands Recruited for “New Era” Severe Mental Illness Study
Thousands of people living with schizophrenia and severe depression are being recruited by the NHS for a major new study which could unlock a “new era” of personalised treatment for severe mental illness. As part of the world’s largest mental health study, researchers...
THX Pharma and Biocodex Sign Licensing Deal for Batten-1 and TX01 Therapies
THX Pharma (formerly known as Theranexus) has entered into a strategic licensing agreement with French pharmaceutical company Biocodex covering two experimental programs, Batten-1 and TX01, in a move aimed at accelerating development and expanding commercial reach....
Chronic Pain and Neuroplastic Pain: Rethinking How Pain is Created
Chronic pain affects hundreds of millions of people worldwide and remains one of the most challenging problems in modern medicine. For decades, pain has largely been understood as a direct signal of tissue damage or disease. However, advances in pain science are...
Beyond Hallucinated Binders: The Enzymatic Frontier for Generative AI
Generative AI has already changed what is possible in protein engineering. In the last few years, the field has moved from predicting protein structures to proposing entirely new proteins, often with experimentally verified folding and binding, at a pace that was...
Neuroscience of Trauma, Stress & Alcohol: Integrated Treatment
Alcohol problems are often framed as a failure of willpower or “poor lifestyle choices”. Yet clinical neuroscience has made that narrative increasingly untenable. Problematic alcohol use is often a learned response to stress, a learned neurobiological adaptation,...
Auxilium and MBI Launch Life Sciences Accelerator Cohort in Worcester
Auxilium and Massachusetts Biomedical Initiatives (MBI) have announced a joint life sciences accelerator cohort in Worcester designed to attract and support founders developing the next generation of healthcare and life sciences technologies. Founders selected for the...
Further News
Want to Be Part of the Next Chapter in Life Sciences Media?
LifeScienceDaily.news is building a new kind of platform where innovators, researchers, and industry leaders tell their own stories and shape the narrative of what’s next in life sciences. Share your story and lead the conversation.
Don’t wait for the media to pick up your story. Be the media.
See More Articles
Want to Be Part of the Next Chapter in Life Sciences Media?
LifeScienceDaily.news is building a new kind of platform where innovators, researchers, and industry leaders tell their own stories and shape the narrative of what’s next in life sciences. Share your story and lead the conversation.